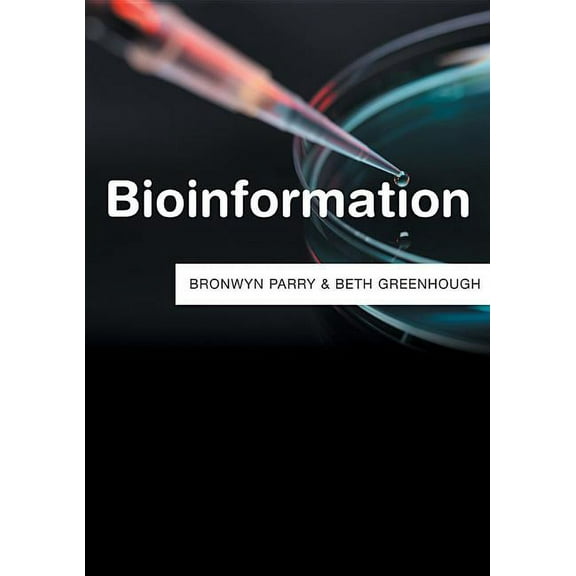
Bioinformation

Bioinformation(10)
Uses item details. Price when purchased online
Bioinformation
Bioinformation
Bioinformation Discovery: Data to Knowledge in Biology, (Paperback) $97.01 Was $113.85

Now$9701
current price Now $97.01, Was $113.85$113.85
Bioinformation Discovery: Data to Knowledge in Biology, (Paperback)
Bioinformation Discovery: Data to Knowledge in Biology, (Hardcover) $90.12

$9012
current price $90.12Bioinformation Discovery: Data to Knowledge in Biology, (Hardcover)
Bioinformation Discovery: Data to Knowledge in Biology, (Paperback) $120.83 Was $154.90

Now$12083
current price Now $120.83, Was $154.90$154.90
Bioinformation Discovery: Data to Knowledge in Biology, (Paperback)
Bioinformation Computing of Lactic Acid Bacteria and Intelligent Algorithm Optimization (Paperback) $60.00

$6000
current price $60.00Bioinformation Computing of Lactic Acid Bacteria and Intelligent Algorithm Optimization (Paperback)
Routledge Studies in Anthropology Bioinformation Worlds and Futures, (Paperback) $57.99

$5799
current price $57.99Routledge Studies in Anthropology Bioinformation Worlds and Futures, (Paperback)
Cognitive Science and Technology Bioinformation Processing: A Primer on Computational Cognitive Science, (Paperback) $135.17

$13517
current price $135.17Cognitive Science and Technology Bioinformation Processing: A Primer on Computational Cognitive Science, (Paperback)
Cognitive Science and Technology Bioinformation Processing: A Primer on Computational Cognitive Science, (Hardcover) $164.18

$16418
current price $164.18Cognitive Science and Technology Bioinformation Processing: A Primer on Computational Cognitive Science, (Hardcover)
Resources: Bioinformation (Hardcover) $66.19

$6619
current price $66.19Resources: Bioinformation (Hardcover)
Technik, Wirtschaft Und Politik Bioinformation: Problemlsungen Fr Die Wissensgesellschaft, Book 38, (Paperback) $59.99

$5999
current price $59.99Technik, Wirtschaft Und Politik Bioinformation: Problemlsungen Fr Die Wissensgesellschaft, Book 38, (Paperback)
Other options to consider(1)
Current Topics in Environmental Health a Bio-Information for Hygiene, (Hardcover) $136.86 Was $159.99

Now$13686
current price Now $136.86, Was $159.99$159.99
Current Topics in Environmental Health a Bio-Information for Hygiene, (Hardcover)
Related Products
Social Morphogenesis Morphogenesis and the Crisis of Normativity, (Hardcover)
Social Morphogenesis Morphogenesis and the Crisis of Normativity, (Hardcover)$107.90current price $107.90Myopia : Optics, Clinical Presentation and Management
Myopia : Optics, Clinical Presentation and Management$226.21current price $226.21Thermodynamics and Energy Engineering (Hardcover)
Thermodynamics and Energy Engineering (Hardcover)$141.40current price $141.40The Mature Student's Guide to Tackling a Post-Secondary Education, (Paperback)
The Mature Student's Guide to Tackling a Post-Secondary Education, (Paperback)$7.14current price $7.14Cambridge Studies in Biological and Evol Shaping Primate Evolution: Form, Function, and Behavior, Book 40, (Hardcover)
Cambridge Studies in Biological and Evol Shaping Primate Evolution: Form, Function, and Behavior, Book 40, (Hardcover)$120.86current price $120.86Adaptive Finance: Embracing Uncertainty and Complexity, (Paperback)
Adaptive Finance: Embracing Uncertainty and Complexity, (Paperback)$52.72current price $52.72Entwicklung eines Bewertungssystems für die ökonomische und ökologische Erneuerung von Wohnungsbeständen, (Paperback)
Entwicklung eines Bewertungssystems für die ökonomische und ökologische Erneuerung von Wohnungsbeständen, (Paperback)$51.92current price $51.92Axons : Cell Biology, Molecular Dynamics and Roles in Neural Repair and Rehabilitation
Axons : Cell Biology, Molecular Dynamics and Roles in Neural Repair and Rehabilitation$168.17current price $168.17
